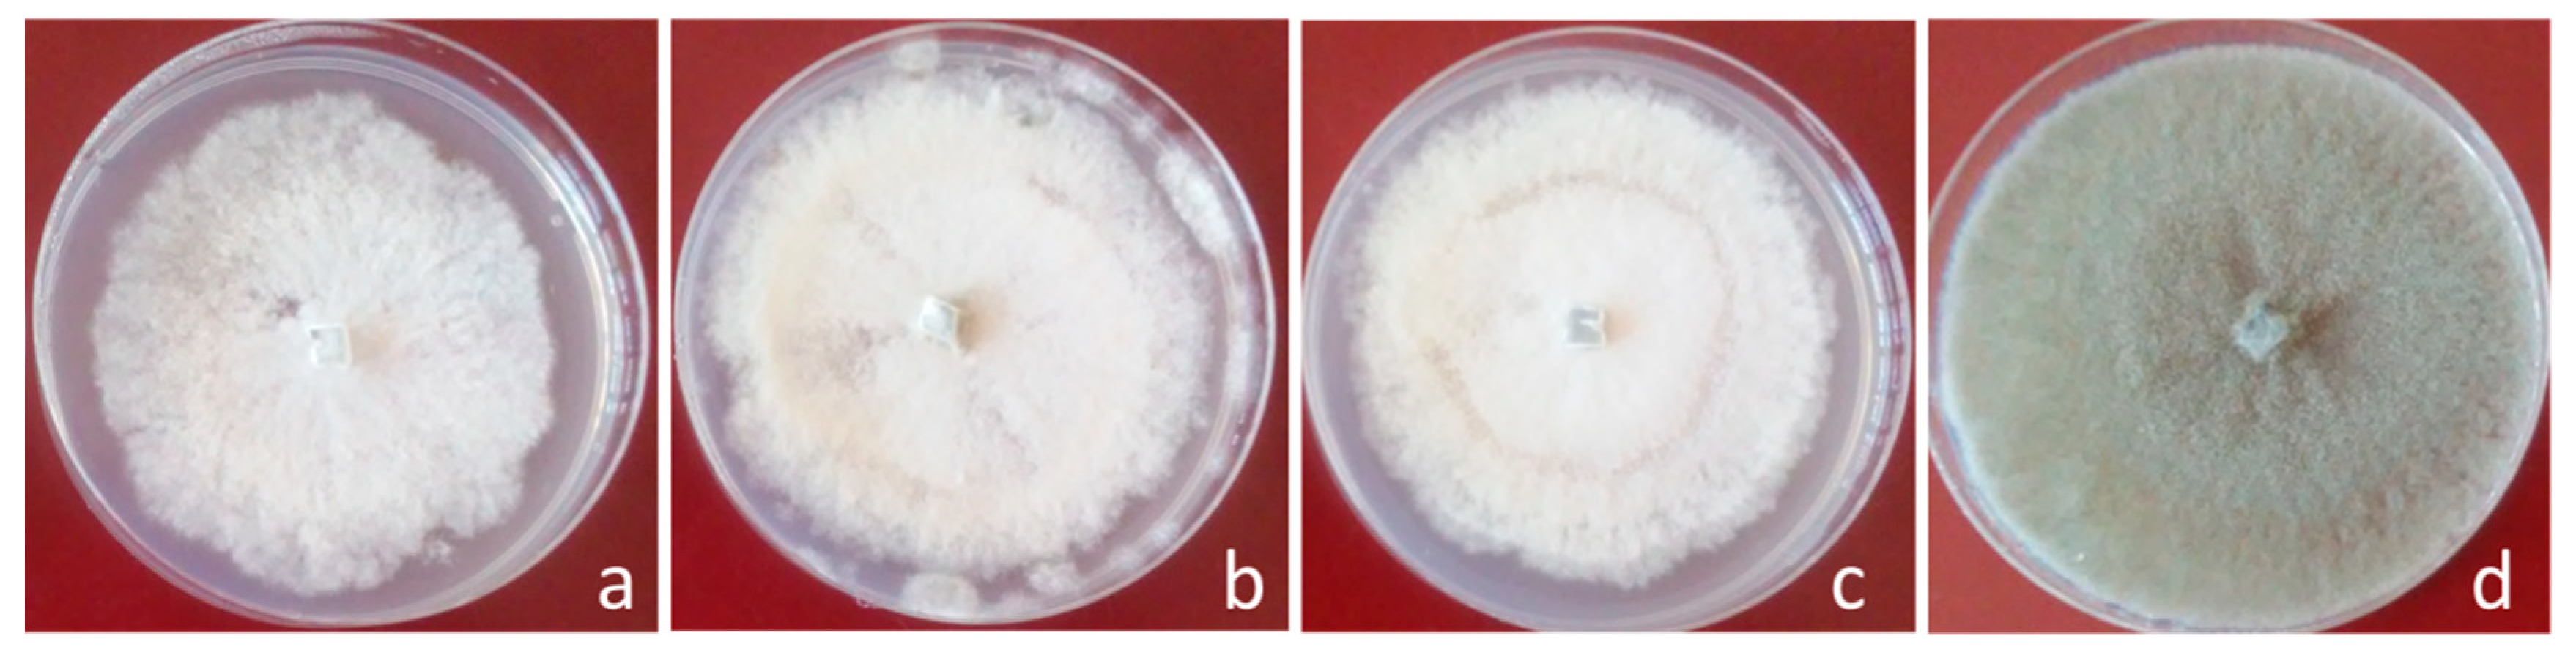
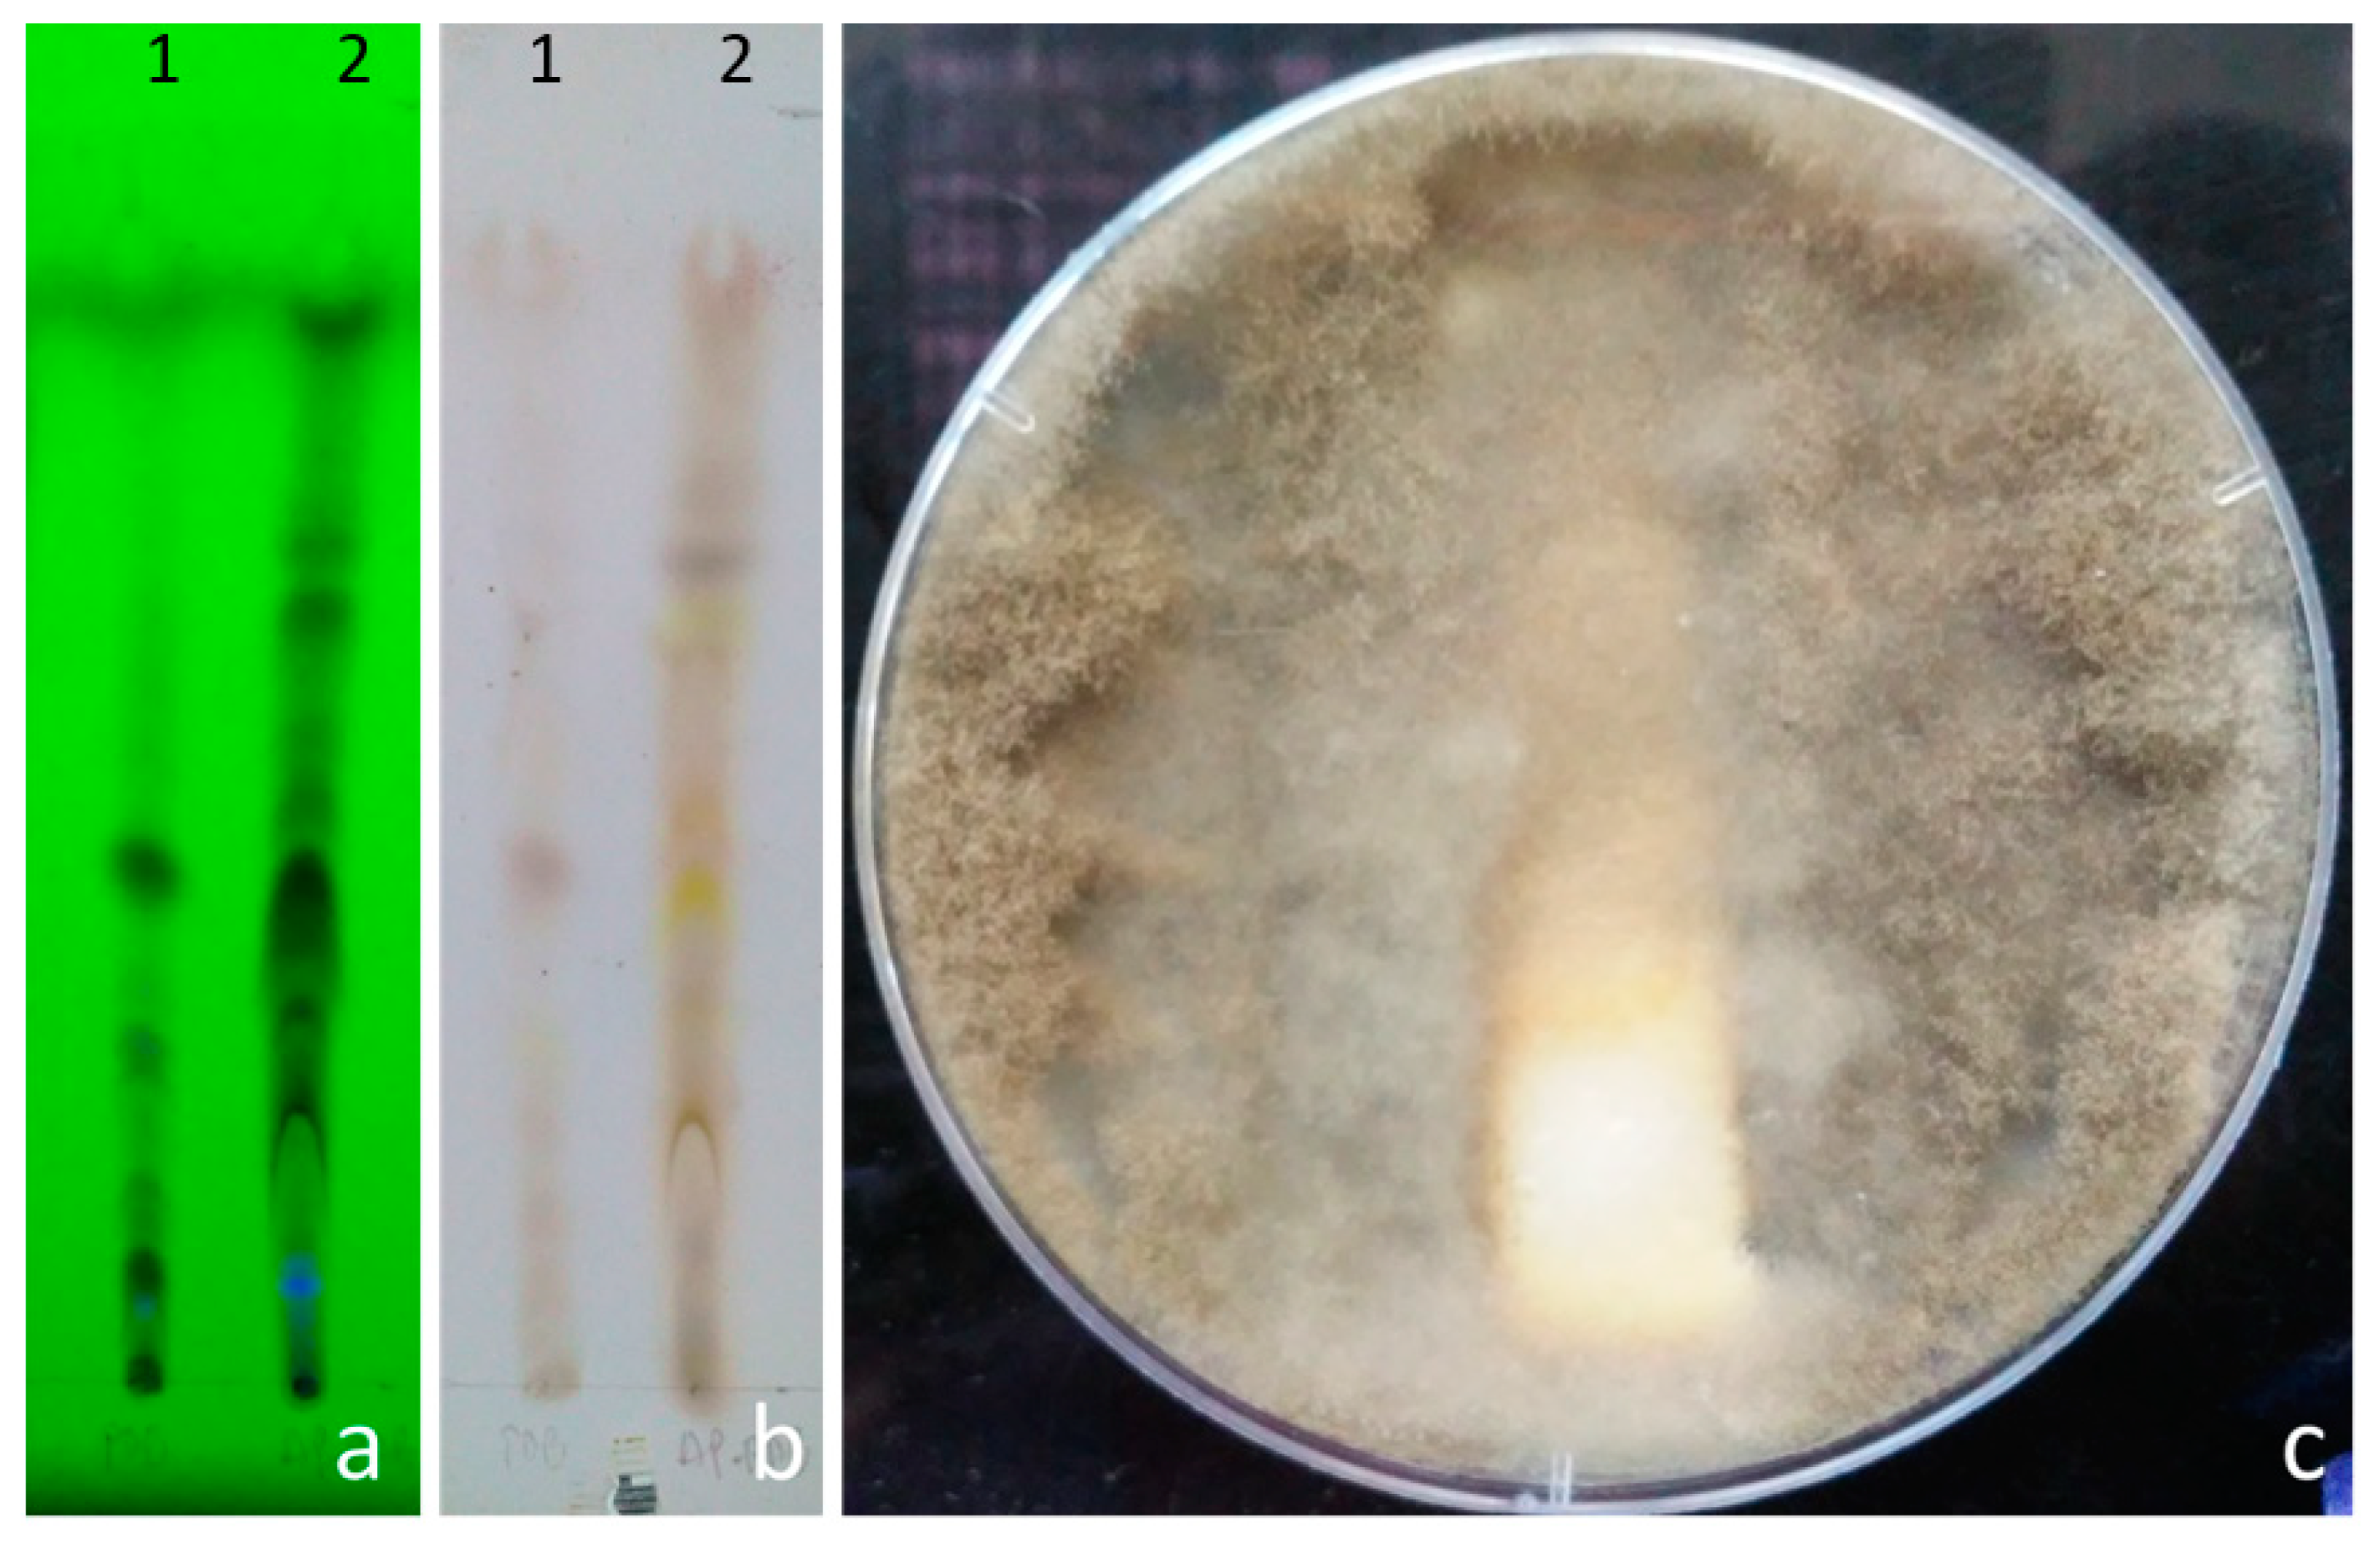

Endophytic Fungi Isolated from Plants Growing in Central Andean Precordillera of Chile with Antifungal Activity against Botrytis cinerea
Abstract
1. Introduction
2. Materials and Methods
2.1. Collection of Plant Material
2.2. Isolation of Endophytic Fungi
2.3. Antifungal Activity Determination against B. cinerea
2.3.1. Dual Confrontation Assay
2.3.2. Effect of Volatile Compounds on the Growth of B. cinerea
2.3.3. Effect of Volatile Compounds on the Sporulation of B. cinerea
2.3.4. Effect of Diffusible Compounds on Growth and Germination of B. cinerea
2.4. Identification of Endophytic Fungi
2.5. Statistical Analysis
3. Results
3.1. Isolation of Endophytic Fungi
3.2. Morphological Identification of Endophytic Fungi with Antifungal Activity
4. Discussion
5. Conclusions
Supplementary Materials
Author Contributions
Funding
Acknowledgments
Conflicts of Interest
References
- Dean, R.; van Kan, J.A.; Pretorius, Z.A.; Hammond-Kosack, K.E.; Di Pietro, A.; Spanu, P.D. The Top 10 fungal pathogens in molecular plant pathology. Mol. Plant. Pathol. 2012, 13, 414–430. [Google Scholar] [CrossRef] [PubMed]
- Jacometti, M.A.; Wratten, S.D.; Walter, M. Review: Alternatives to synthetic fungicides for Botrytis cinerea management in vineyards. Aust. J. Grape Wine Res. 2010, 16, 154–172. [Google Scholar] [CrossRef]
- Hahn, M. The rising threat of fungicide resistance in plant pathogenic fungi: Botrytis as a case study. J. Biol. Chem. 2014, 7, 133–141. [Google Scholar] [CrossRef] [PubMed]
- Esterio, M.; Copier, C.; Román, A.; Araneda, M.; Rubilar, M.; Pérez, I.; Auger, J. Frequency of fungicide-resistant Botrytis cinerea populations isolated from ‘Thompson Seedless’ table grapes in the Central Valley of Chile. Cienc. Investig. Agrar. 2017, 44, 295–306. [Google Scholar] [CrossRef][Green Version]
- Deshmukh, S.; Gupta, M.; Prakash, V.; Saxena, S. Endophytic Fungi: A source of potential antifungal compounds. J. Fungi 2018, 4, 77. [Google Scholar] [CrossRef] [PubMed]
- Jia, M.; Chen, L.; Xin, H.; Zheng, C.; Rahman, K.; Han, T.; Qin, L. A Friendly relationship between endophytic fungi and medicinal plants: A systematic review. Front. Microbiol. 2016, 7, 1–14. [Google Scholar] [CrossRef]
- Bolívar-Anillo, H.J.; Garrido, C.; Collado, I.G. Endophytic microorganisms for biocontrol of the phytopathogenic fungus Botrytis cinerea. Phytochem. Rev. 2019, 19, 721–740. [Google Scholar] [CrossRef]
- Strobel, G. Endophytes as sources of bioactive products. Microbes Infect. 2003, 5, 535–544. [Google Scholar] [CrossRef]
- Castri, F.; Mooney, H.A. Mediterranean Type Ecosystems: Origin and Structure; Springer: Berlin/Heidelberg, Germany, 1973. [Google Scholar]
- Dallman, P.R. Plant Life in the World’s Mediterranean Climates: California, Chile, South Africa, Australia, and the Mediterranean Basin; Oxford University Press: Oxford, UK, 1998. [Google Scholar]
- Nardini, A.; Lo Gullo, M.A.; Trifilò, P.; Salleo, S. The challenge of the Mediterranean climate to plant hydraulics: Responses and adaptations. Env. Exp. Bot. 2014, 103, 68–79. [Google Scholar] [CrossRef]
- Suryanarayanan, T.S.; Wittlinger, S.K.; Faeth, S.H. Endophytic fungi associated with cacti in Arizona. Mycol. Res. 2005, 109, 635–639. [Google Scholar] [CrossRef]
- Muñoz, G.; Hinrichsen, P.; Brygoo, Y.; Giraud, T. Genetic characterization of Botrytis cinereal populations in Chile. Mycol. Res. 2002, 106, 594–601. [Google Scholar] [CrossRef]
- Montealegre, J.; Ochoa, F.; Besoain, X.; Herrera, R.; Pérez, L. In Vitro and glasshouse biocontrol of Rhizoctonia solani with improved strains of Trichoderma spp. Cienc. Investig. Agrar. 2014, 41, 197–206. [Google Scholar] [CrossRef][Green Version]
- Chen, P.H.; Chen, R.Y.; Chou, J.Y. Screening and evaluation of yeast antagonists for biological control of Botrytis cinerea on strawberry fruits. Mycobiology 2018, 46, 33–46. [Google Scholar] [CrossRef] [PubMed]
- Li, N.; Alfiky, A.; Wang, W.; Islam, M.; Nourollahi, K.; Liu, X.; Kang, S. Volatile compound-mediated recognition and inhibition between Trichoderma biocontrol agents and Fusarium Oxysporum. Front. Microbiol. 2018, 9, 2614. [Google Scholar] [CrossRef] [PubMed]
- Rubio, M.B.; Hermosa, R.; Reino, J.L.; Collado, I.G.; Monte, E. Thctf1 transcription factor of Trichoderma harzianum is involved in 6-pentyl-2H-pyran-2-one production and antifungal activity. Fungal Genet. Biol. 2009, 46, 17–27. [Google Scholar] [CrossRef] [PubMed]
- Gao, P.; Qin, J.; Li, D.; Zhou, S. Inhibitory effect and possible mechanism of a Pseudomonas strain QBA5 against gray mold on tomato leaves and fruits caused by Botrytis cinerea. PLoS ONE 2018, 13, e0190932. [Google Scholar] [CrossRef]
- Morales, J.; Mendoza, L.; Cotoras, M. Alteration of oxidative phosphorylation as a possible mechanism of the antifungal action of p-coumaric acid against Botrytis cinerea. J. Appl. Microbiol. 2017, 123, 969–976. [Google Scholar] [CrossRef]
- Dissanayak, M.L.M.C.; Ito, S.I.; Yoshihiko, A. TLC Bioautography guided detection and biological activity of antifungal compounds from medicinal plant Acorus calamus Linn. Asian J. Plant. Pathol. 2015, 9, 16–26. [Google Scholar] [CrossRef][Green Version]
- Doyle, J.J.; Doyle, J.L. Isolation of plant DNA from fresh tissue. Focus 1990, 12, 13–15. [Google Scholar]
- White, T.; Bruns, T.; Lee, S.; Taylor, J. Amplification and Direct Sequencing of Fungal Ribosomal Rna Genes for Phylogenetics. Pcr Protocols: A Guide to Methods and Applications; New York Academic Press Inc.: New York, NY, USA, 1990; pp. 315–322. [Google Scholar]
- Altschul, S.F.; Gish, W.; Miller, W.; Myers, E.W.; Lipman, D.J. Basic local alignment search tool. J. Mol. Biol. 1990, 215, 403–410. [Google Scholar] [CrossRef]
- Saitou, N.; Nei, M. The neighbor-joining method: A new method for reconstructing phylogenetic trees. Mol. Biol. Evol. 1987, 4, 406–425. [Google Scholar] [PubMed]
- Agrios, G.N. Plant Pathology, 5th ed.; Elsevier Acad. Press: Boston, MA, USA, 2005. [Google Scholar]
- Deacon, J.W. Fungal Biology, 4th ed.; Blackwell Publishing Ltd.: Oxford, UK, 2006. [Google Scholar]
- Hoog, G.; Horre, R. Molecular taxonomy of the Alternaria and Ulocladium species from humans and their identification in the routine laboratory. Mycoses 2002, 45, 259–276. [Google Scholar] [CrossRef] [PubMed]
- Zhu, X.; Xiao, C. Phylogenetic, morphological, and pathogenic characterization of Alternaria Species associated with fruit rot of blueberry in California. Phytopathology 2015, 105, 1555–1567. [Google Scholar] [CrossRef]
- Zalar, P.; Gostinčar, C.; de Hoog, G.S.; Uršič, V.; Sudhadham, M.; Gunde-Cimerman, N. Redefinition of Aureobasidium pullulans and its varieties. Stud. Mycol. 2008, 61, 21–38. [Google Scholar] [CrossRef] [PubMed]
- Peña-Rojas, K.; Donoso, S.; Pacheco, C.; Riquelme, A.; Gangas, R.; Guajardo, A.; Durán, S. Respuestas morfo-fisiológicas de plantas de Lithraea caustica (Anacardiaceae) sometidas a restricción hídrica controlada. Bosque (Valdivia) 2018, 39, 27–36. [Google Scholar] [CrossRef]
- Higgins, K.L.; Arnold, A.E.; Miadlikowska, J.; Sarvate, S.D.; François, L. Phylogenetic relationships, host affinity, and geographic structure of boreal and arctic endophytes from three major plant lineages. Mol. Phylogenet. Evol. 2007, 42, 543–555. [Google Scholar] [CrossRef]
- Arnold, A.E.; Lutzoni, F. Diversity and host range of foliar fungal endophytes: Are tropical leaves biodiversity hotspots? Ecology 2007, 88, 541–549. [Google Scholar] [CrossRef]
- Moricca, S.; Ragazzi, A. Fungal endophytes in Mediterranean oak forests: A lesson from Discula quercina. Phytopathology 2008, 98, 380–386. [Google Scholar] [CrossRef]
- Linaldeddu, B.T.; Sirca, C.; Spano, D.; Franceschini, A. Variation of endophytic cork oak-associated fungal communities in relation to plant health and water stress. Pathology 2011, 41, 193–201. [Google Scholar] [CrossRef][Green Version]
- Martinez-Alvarez, P.; Martin-Garcia, J.; Rodriguez-Ceinos, S.; Diez, J.J. Monitoring endophyte populations in pine plantations and native oak forests in Northern Spain. For. Syst. 2012, 21, 373–382. [Google Scholar] [CrossRef]
- Moricca, S.; Ginetti, B.; Ragazzi, A. Species and organ specificity in endophytes colonizing healthy and declining Mediterranean oaks. Phytopathol. Mediterr. 2012, 51, 587–598. [Google Scholar]
- Maciá-Vicente, J.G.; Jansson, H.B.; Abdullah, S.K.; Descals, E.; Salinas, J.; Lopez-Llorca, L.V. Fungal root endophytes from natural vegetation in Mediterranean environments with special reference to Fusarium spp. Fems Microbiol. Ecol. 2008, 64, 90–105. [Google Scholar] [CrossRef] [PubMed]
- Cares, R.A.; Medel, R.; Botto-Maham, C. Frugivory in Echinopsis chiloensis (Caryophyllales: Cactaceae). Rev. Chil Hist Nat. 2013, 86, 489–491. [Google Scholar] [CrossRef][Green Version]
- Root-Bernstein, M.; Valenzuela, R.; Huerta, M.; Armesto, J.; Jaksic, F. Acacia caven nurses endemic sclerophyllous trees along a successional pathway from silvopastoral savanna to forest. Ecosphere 2017, 8, e01667. [Google Scholar] [CrossRef]
- Cosoveanu, A.; Cabrera, Y.; Hernandez, G.; Cabrera, R. Endophytic fungi from grapevine cultivars in Canary Islands and their activity against phytopatogenic fungi. Int. J. Agric. Crop. Sci. 2014, 7, 1497–1503. [Google Scholar]
- González-Teuber, M.; Vilo, C.; Bascuñán-Godoy, L. Molecular characterization of endophytic fungi associated with the roots of Chenopodium quinoa inhabiting the Atacama Desert, Chile. Genom. Data 2017, 11, 109–112. [Google Scholar] [CrossRef]
- Oses, R.; Valenzuela, S.; Freer, J.; Sanfuentes, E.; Rodríguez, J. Fungal endophytes in xylem of healthy Chilean trees and their possible role in early wood decay. Fungal Divers. 2008, 33, 77–86. [Google Scholar]
- Hormazabal, E.; Piontelli, E. Endophytic fungi from Chilean native gymnosperms: Antimicrobial activity against human and phytopathogenic fungi. World J. Microb. Biot. 2009, 25, 813–819. [Google Scholar] [CrossRef]
- Schmeda-Hirschmann, G.; Hormazabal, E.; Astudillo, L.; Rodriguez, J.; Theoduloz, C. Secondary metabolites from endophytic fungi isolated from the Chilean gymnosperm Prumnopitys Andin. (Lleuque). World J. Microbiol. Biotechnol. 2005, 21, 27–32. [Google Scholar] [CrossRef]
- Eram, D.; Arthikala, M.; Melappa, G.; Santoyo, G. Alternaria species: Endophytic fungi as alternative sources of bioactive compounds. Ital. J. Mycol. 2018, 47, 40–54. [Google Scholar]
- Chowdhary, K.; Kaushik, N. Fungal endophyte diversity and bioactivity in the Indian medicinal plant Ocimum sanctum Linn. PLoS ONE 2015, 10, e0141444. [Google Scholar] [CrossRef] [PubMed]
- Park, Y.H.; Kim, Y.; Mishra, R.C.; Bae, H. Fungal endophytes inhabiting mountain-cultivated ginseng (Panax ginseng Meyer): Diversity and biocontrol activity against ginseng pathogens. Sci. Rep. 2017, 7, 1–10. [Google Scholar] [CrossRef] [PubMed]
- Bozoudi, D.; Tsaltas, D. The multiple and versatile roles of Aureobasidium pullulans in the vitivinicultural sector. Fermentation 2018, 4, 85. [Google Scholar] [CrossRef]
- Di Francesco, A.; Ugolini, L.; D’Aquino, S.; Pagnotta, E.; Mari, M. Biocontrol of Monilinia laxa by Aureobasidium pullulans strains: Insights on competition for nutrients and space. Int. J. Food Microbiol. 2017, 248, 32–38. [Google Scholar] [CrossRef] [PubMed]
- Lou, J.; Fu, L.; Peng, Y.; Zhou, L. Metabolites from Alternaria fungi and their bioactivities. Molecules 2013, 18, 5891–5935. [Google Scholar] [CrossRef]
- Feng, C.; Ma, Y. Isolation and anti-phytopathogenic activity of secondary metabolites from Alternaria sp. FL25, an endophytic fungus in Ficus carica. Chin. J. Appl. Environ. Biol. 2010, 16, 76–78. [Google Scholar] [CrossRef]
- Prasongsuk, S.; Lotrakul, P.; Ali, I.; Bankeeree, W.; Punnapayak, H. The current status of Aureobasidium pullulans in biotechnology. Folia Microbiol. 2018, 63, 129–140. [Google Scholar] [CrossRef]
- Di Francesco, A.; Ugolini, L.; Lazzer, L.; Mari, M. Production of volatile organic compounds by Aureobasidium pullulans as a potential mechanism of action against postharvest fruit pathogens. Biol. Control. 2015, 81, 8–14. [Google Scholar] [CrossRef]
- Gostinčar, C.; Ohm, R.A.; Kogej, T.; Sonjak, S.; Turk, M.; Zajc, J.; Gunde-Cimerman, N. Genome sequencing of four Aureobasidium pullulans varieties: Biotechnological potential, stress tolerance, and description of new species. BMC Genom. 2014, 15, 549. [Google Scholar] [CrossRef]

| Plant | Isolation Organ | Fungal Isolate | Growth Type |
|---|---|---|---|
| C. polifolia | Leaf | Cp1 | Filamentous |
| L. caustica | Leaf | Lc1 | Filamentous |
| C. odorifera | Leaf | Co1 | Filamentous |
| E. chiloensis | Stem | Ec1 | Filamentous |
| T. tricolor | Flower | Tt1 | Filamentous |
| Stem | Tt2 | Filamentous | |
| Flower | Tt3 | Yeast | |
| Stem | Tt4 | Yeast | |
| P. chilensis | Flower | Pc1 | Filamentous |
| Stem | Pc2 | Yeast | |
| A. caven | Stem | Ac1 | Filamentous |
| Fungal Endophyte | Inhibition of Mycelial Growth in the Confrontation Test (%) | Inhibition of Mycelial Growth Produced by Volatile Compounds (%) |
|---|---|---|
| Lc1 | 36.0 ± 4.0 | 22.4 ± 3.5 |
| Ac1 | 41.9 ± 2.8 | 18.0 ± 3.8 |
| Ec1 | 36.6 ± 4.5 | 17.0 ± 1.5 |
© 2020 by the authors. Licensee MDPI, Basel, Switzerland. This article is an open access article distributed under the terms and conditions of the Creative Commons Attribution (CC BY) license (http://creativecommons.org/licenses/by/4.0/).
Share and Cite
Vidal, A.; Parada, R.; Mendoza, L.; Cotoras, M. Endophytic Fungi Isolated from Plants Growing in Central Andean Precordillera of Chile with Antifungal Activity against Botrytis cinerea. J. Fungi 2020, 6, 149. https://doi.org/10.3390/jof6030149
Vidal A, Parada R, Mendoza L, Cotoras M. Endophytic Fungi Isolated from Plants Growing in Central Andean Precordillera of Chile with Antifungal Activity against Botrytis cinerea. Journal of Fungi. 2020; 6(3):149. https://doi.org/10.3390/jof6030149
Chicago/Turabian StyleVidal, Araceli, Rodolfo Parada, Leonora Mendoza, and Milena Cotoras. 2020. "Endophytic Fungi Isolated from Plants Growing in Central Andean Precordillera of Chile with Antifungal Activity against Botrytis cinerea" Journal of Fungi 6, no. 3: 149. https://doi.org/10.3390/jof6030149
APA StyleVidal, A., Parada, R., Mendoza, L., & Cotoras, M. (2020). Endophytic Fungi Isolated from Plants Growing in Central Andean Precordillera of Chile with Antifungal Activity against Botrytis cinerea. Journal of Fungi, 6(3), 149. https://doi.org/10.3390/jof6030149
